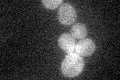
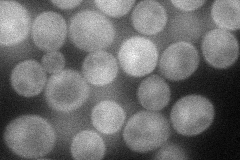
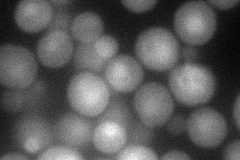
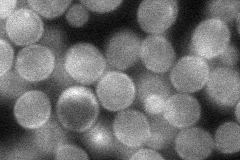
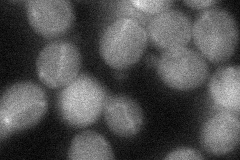
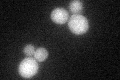
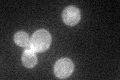

View description
Protein required, with binding partner Psr1p, for full activation of the general stress response, possibly through Msn2p dephosphorylation; regulates growth during the diauxic shift; negative regulator of G1 cyclin expression
Localization:
Intensity:
Fold change:
Significance:
-
C’ GFP library in SD
cell periphery28.33 -
N' NOP1pr-GFP in SD
cell periphery56.0832 -
N' TEF2pr-mCherry in SD
cell periphery,nucleus64.0267 -
N' NATIVEpr-GFP in SD
cell periphery47.3175 -
N' TEF2pr-VC and Cyto-VN in SD
cytosol40.2666 -
C’ GFP library in SD+DTT
cell periphery28.270.99No -
C’ GFP library in SD+H2O2

cell periphery28.81.01No -
C’ GFP library in Starvation Media
cell periphery44.871.58Yes -
C’ GFP library on the background of Pup2-DaMP

cell periphery -
C’ GFP library on the background of CCT mutant

cell periphery34.53791.21877No
